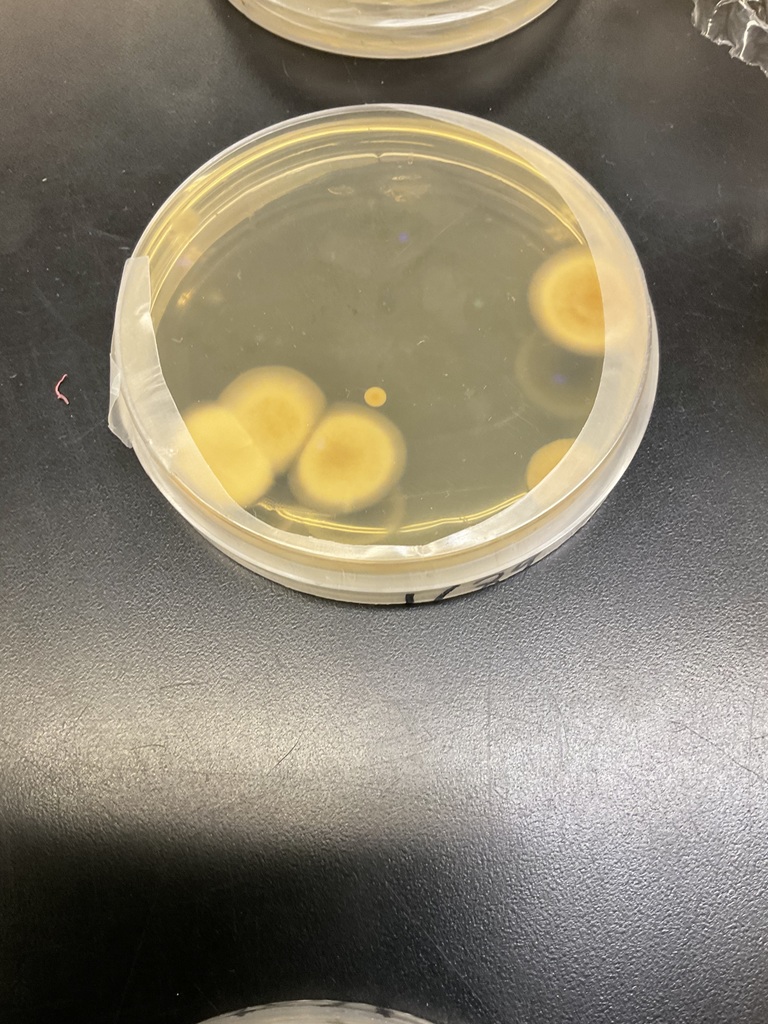
Microbiology

Are we shelf safe? The biology class checks the growth of swabbed juices, both UHT (Ultra-high Temperature) shelf-safe and fresh fruits, to see how many colonies have grown. How many can you count?

Basketball changes for this Thursday and Friday:
Thursday - STK vs. Burwell: 1 qtr of JV girls at 4:45 and 2 qtrs JV boys to follow. V girls will start at approx. 6pm with V boys to follow.
Friday - STK vs. Valentine: 2 qtrs of JV girls at 4:30 and 2 qtrs of JV boys to follow. V girls to start at approx. 6pm with V boys to follow.
🎭 Master Storytellers in Action! ✨
Our Creative Writing students traded the classroom for a day of professional inspiration at the Storytelling Festival Workshops at the Regional Engagement Center! 📝🔥
Mrs. Bernardo and three of our Knights—Heath, Josie, and Mason—dived into masterclasses led by two of the industry’s most renowned voices:
➡️ Lyn Ford (Ohio) 🌰: A fourth-generation storyteller, "Affrilachian" teaching artist, and recipient of the National Storytelling Network’s Circle of Excellence Award. She shared her centuries-old traditions, teaching the group that empathetic communication is truly the "heart of storytelling".
➡️ Paul Strickland (Kentucky) 🐎: An 18-time "Best of Fest" winner and professional theatre artist. Paul demonstrated how to use "curiosity questions" to hook an audience and transform "I don’t know" into a doorway for creativity.
The group took a midday break to refuel with a fantastic sushi and hibachi lunch 🍣🍱—the perfect opportunity to workshop ideas and prep for the afternoon session!
A huge shout out to Mr. Moody for getting the group there safely 🚐💨, and a sincere thank you to our school leadership for supporting this unique opportunity! Can’t wait to see these world-class techniques come to life in our students' writing. ✍️🌟
#SandhillKnights #CreativeWriting #StorytellingFestival #FutureAuthors #HandsOnLearning










Congratulations to all of our Spelling Bee spellers!
Great job to everyone who participated yesterday! 🐝
Here are the results from each class and overall!
Great job to everyone who participated yesterday! 🐝
Here are the results from each class and overall!

The Noble Times - February 1, 2026 - Volume 5
Written by: Thatcher Teahon, Shaylee Milleson, Hunter Bray, and Sophia Glidden.




Spelling Bee Tomorrow!
Join us Tuesday, February 3rd, 2026, at 9:00 AM in the Halsey Gym as our 2nd–8th grade students compete in the annual Spelling Bee.
Best of luck to all our spellers!
Join us Tuesday, February 3rd, 2026, at 9:00 AM in the Halsey Gym as our 2nd–8th grade students compete in the annual Spelling Bee.
Best of luck to all our spellers!

The wrestlers had some great showings on Friday and Saturday.
The boys started out on Friday in Ord.
Caleb was able to come away with a second place finish on the day!
Saturday, both boys and girls competed at Doniphan-Trumbull.
Boys:
Braydyn - 4th Place
Caleb - 2nd Place
Girls:
Jordyn - 2nd Place
Sophia - 2nd Place
Shaylee - 2nd Place
HayLynn - 1st Place
Mattee - 1st Place
Their hard work paid off with the girls coming in 2nd as a team!
Congrats to all on all of your hard work!!
Up coming: The boys travel to Leigh for a tournament on Friday as the girls travel to Ogallala for districts on Friday AND Saturday! Good luck!!









Both girls & boys wrestling teams are headed to Doniphan-Trumbull today!
🕘 Start time: 9:00 AM
📺 Live stream: https://fan.hudl.com/usa/ne/doniphan/organization/637/doniphan-trumbull-high-school
Good luck, wrestlers! 💪
🕘 Start time: 9:00 AM
📺 Live stream: https://fan.hudl.com/usa/ne/doniphan/organization/637/doniphan-trumbull-high-school
Good luck, wrestlers! 💪
It’s meet day! Best of luck to our wrestlers competing today in Ord starting at 10 AM! 💪🤼♀️
If you can’t be there in person, catch the action live:
https://youtube.com/ChanticleerStreaming
Let’s go!
If you can’t be there in person, catch the action live:
https://youtube.com/ChanticleerStreaming
Let’s go!
Your Lady Knights fought hard but came up short tonight to the Brady Eagles. 47-42. Good luck on Saturday ladies.

Your Sandhills-Thedford boy's rolled the Mullen Broncos 59-37 in MNAC action today. Great win, see you Saturday in the finals!

Yesterday Sandhills FFA members traveled to North Platte for the Career Development Event. They had a great day! Thanks so much to our Meats coach Mallory Sikes for her help with preparation and help with supervision at the contest!
Results:
Floriculture: Mattee, Paizley, Cora and Tyla Placed 5th (State Qualifier!!!!)
Individual Ribbons: Paizley- Purple. Mattee-Blue
Meats: Cesar, Heath, Sophia and Hunter Placed 2nd (State Qualifier!!!!!)
Individual Ribbons: Heath-Purple, Sophia-Blue, Cesar-Red, Hunter-White
Natural Resources: Peyton, Alex, Sophia, Heath. Heath Received a White Ribbon
Welding: Aaron and Colton: Colton Received 5th place and a Red Ribbon in Stick Welding
Livestock Management: Tyla, Paizley, Colton, Mattee, and Cora: Received 3rd and Red Ribbons in the categories of Swine and Beef.
Results:
Floriculture: Mattee, Paizley, Cora and Tyla Placed 5th (State Qualifier!!!!)
Individual Ribbons: Paizley- Purple. Mattee-Blue
Meats: Cesar, Heath, Sophia and Hunter Placed 2nd (State Qualifier!!!!!)
Individual Ribbons: Heath-Purple, Sophia-Blue, Cesar-Red, Hunter-White
Natural Resources: Peyton, Alex, Sophia, Heath. Heath Received a White Ribbon
Welding: Aaron and Colton: Colton Received 5th place and a Red Ribbon in Stick Welding
Livestock Management: Tyla, Paizley, Colton, Mattee, and Cora: Received 3rd and Red Ribbons in the categories of Swine and Beef.






The Biology class is working on Microbiology and Microorganisms growing on agar plates from fruit juices and Winogradsky Columns created by former students.




Both teams advance in the MNAC tournament to tomorrow in Broken Bow. Boys will play @ 3PM and Girls will play at 6PM. Go Knights!


MNAC Game 1 in the books. Your Sandhills-Thedford Knights down the Brady Eagles 76-53 in boys action!

Poetry in motion. 🎙️✨
Our #PoetryOutLoud winners just wrapped a masterclass with @NE4Arts legend Petra Wahlqvist.
The energy? Unmatched. The talent? Sharpened. The goal? State. 🏆
Thanks, Mrs. B, for bringing a pro to our class! 🛡️#Preparing4State #NEArts #ELA #Knights



Sandhills Families, due to forecasted wind chills Sandhills Public Schools will be having a 10:00 am start tomorrow, Monday, January 26th. Again, 10:00 am start tomorrow. Busses will run accordingly.
Due to forecasted wind chills, Sandhills Public Schools will be closed tomorrow, January 23rd. There will be no practices.
High school boys wrestling parents and athletes: Due to school closures wrestlers will not travel to South Loup tomorrow.
The basketball games vs. Ainsworth scheduled for Friday, Jan. 23rd are being moved to Saturday the 24th IN Thedford. JV girls will start at 1:00pm (3-6min qtrs) followed by boys JV (3-6min qtrs). There will be senior introductions after JV boys. Girls Varsity will start at approx. 2:45 with V.boys to follow.
